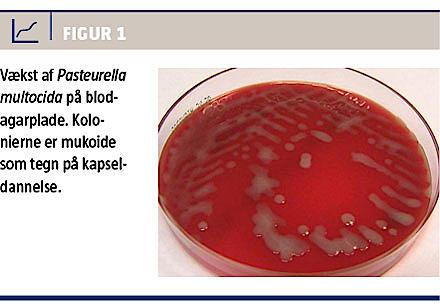

Bakterien Pasteurella multocida er en lille gramnegativ kokkoid stav, som koloniserer svælg og øvre luftveje hos mange dyr [1]. Som navnet indikerer
(multocida = mangedræber), forårsager bakterien alvorlige infektioner hos mange dyrearter. Hos mennesket er der imidlertid hyppigst tale om sårinfektion efter bidtraumer fra især hund og kat (Tabel 1).
I sjældnere tilfælde kan P. multocida dog forårsage mere alvorlig systemisk infektion, især hos en immunkompromitteret patient [2].
SYGEHISTORIE
En 66-årig mand blev akut indlagt med feber, hoste og dyspnø. Han var 18 måneder forinden blevet opereret for en ikkesmåcellet lungecancer, og pga. efterfølgende lokalt recidiv og levermetastaser var han nu påbegyndt pallierende kemoterapi med carboplatin og vinorelbin. Den tredje serie heraf blev påbegyndt 12 dage før indlæggelsen. Ud over sin maligne sygdom havde han methotrexatbehandlet psoriasisartritis, insulinkrævende diabetes og atrieflimren (AFLI). Siden primæroperationen havde han desuden fået flere prednisolonkure, senest en uge før indlæggelsen.
Ved indlæggelsen kunne der høres højresidig inspiratorisk raslen og forlænget eksspiration. Patienten var desuden højfebril (39,7 °C), havde et blodtryk på 94/70 mmHg og en AFLI-frekvens på ca. 150 slag/min. Blodprøver viste koncentrationer af C-reaktivt protein (CRP) på 82 mg/l, leukocytter på 2,9 × 109/l og neutrofilocytter på 2,5 × 109/l. På mistanke om pneumoni og sepsis blev der foretaget dyrkning fra blod og luftvejssekret samt iværksat antibiotisk behandling med ceftriaxon. En røntgenoptagelse af thorax viste efterfølgende basalt højresidigt infiltrat. Patientens tilstand forværredes akut samme aften, hvilket nødvendiggjorde overførsel til intensivafdeling. Dagen efter viste nye blodprøver en kraftig stigning i CRP-koncentrationen (375 mg/l), mens koncentrationen af leukocytter var faldet til 1,0 × 109/l og af neutrofilocytter til 0,75 × 109/l. Hans kliniske tilstand forbedredes langsomt, og efter tre dages understøttende behandling kunne han overføres til stamafdelingen. Efter i alt 15 dages antibiotikabehandling blev han udskrevet i sin habitualtilstand og med leukocytter atter i normalniveau. Bloddyrkning og dyrkning af ekspektorat taget ved indlæggelsen var positive for P. multocida i renkultur (Figur 1).

DISKUSSION
De to isolater af P. multocida blev efterfølgende totalsekventeret på Fødevareinstituttet, Danmarks Tekniske Universitet, hvor man fandt dem identiske, uden kendte antibiotikaresistensgener og tilhørende kapseltype A. Isolaterne tilhørte den genetiske gruppe sekvenstype 74 (ST74), som især er fundet associeret med svin [3].
P. multocida overføres hyppigst fra dyr til mennesker ved direkte kontakt (bid, krads, kys), men også indirekte ved inhalation af aerosoliserede dyresekreter [1]. Patienten benægtede at have haft kontakt med dyr, hvilket også har været tilfældet for patienter i andre sygehistorier. I en nyligt publiceret kasuistik fremføres der bevis for en menneske til menneske-smitte, som måske kan være med til at forklare dette fænomen [4].
P. multocida kan efter overførsel kolonisere de øvre luftveje og især medføre symptomgivende luftvejsinfektioner hos patienter med kroniske lungesygdomme og lungekræft [1]. P. multocida var ikke tidligere blevet fundet i luftvejssekreterne hos patienten i sygehistorien, hvilket tyder på nylig smitte. Patientens pneumoni kompliceredes af sepsis. I en nylig gennemgang af sygehistorier med P. multocida-bakteriæmi var luftvejsinfektion det næsthyppigste bakteriæmiske fokus, kun overgået – forudsigeligt – af hud- og bløddelsinfektioner. Kontakt med dyr var dokumenteret i 82% af tilfældene. Den typiske patient var ældre og havde betydende underliggende sygdom som f.eks. cirrose og malignitet, mens 8% havde diabetes. Mortaliteten var på 23%, hvoraf de fleste havde betydende systemisk eller lokal immunsuppression [5].
Det er som regel kun i tilfælde af nyligt dyrebid, at P. multocida bliver overvejet i den initiale indlæggelsesdiagnose hos patienter med sepsis. Til trods for dette har patienterne typisk fået dækkende initial antibiotikabehandling. Dette skyldes udelukkende
P. multocidas høje følsomhed for betalaktamantibiotika, som hyppigt benyttes ved empirisk sepsisbehandling. Penicillin betragtes som førstevalg ved behandling af P. multocida [1].
P. multocida bør især overvejes som potentiel infektiøst agens hos en immunkompromitteret septisk patient, hvis vedkommende har haft kontakt med dyr. Alvorlig infektion kan dog også opstå uden kontakt med dyr. Nylig observation af smitte imellem mennesker understreger desuden vigtigheden af god håndhygiejne hos patienter i en immunkompromitteret tilstand, f.eks. i perioder med kemoterapiinduceret leukopeni.
KORRESPONDANCE: Marie Bjødstrup Jensen, Mikrobiologisk Afdeling Midt-Vest, Regionshospitalet Herning, Gl. Landevej 61, 7400 Herning.
E-mail: marie_bjoedstrup@hotmail.com
ANTAGET: 5. marts 2013
Publiceret på Ugeskriftet.dk: 22. juli 2013
INTERESSEKONFLIKTER: ingen.
<h2>LITTERATUR</h2>
<ol type="d">
<li><p>Klein NC, Cunha BA. Pasteurella multocida pneumonia. Semin Respir Infect 1997;12:54-6.</p></li>
<li><p>Vélez M, Casanasa B, Greene JN et al. Pasteurella multocida infections in cancer patients. Asian Biomed (Res Rev News) 2010;4:449-55.</p></li>
<li><p>Pors SE, Hansen MS, Christensen H et al. Genetic diversity and associated pathology of Pasteurella multocida isolated from porcine pneumonia. Vet Microbiol 2011;150:354-61.</p></li>
<li><p>Siahanidou T, Gika G, Skiathitou A et al. Pasteurella multocida infection in a neonate. Pediatr Infect Dis J 2012;31:536-7.</p></li>
<li><p>Vondra MS, Myers JP. Pasteurella multocida bacteremia. Infect Dis Clin Pract 2011;19:197-203.</p></li>
</ol>
Pasteurella multocida inhabits the upper respiratory tract of many animals. It can cause skin and soft tissue infections in humans, usually in association with animal bites. We present a case of a 66-year-old chemotherapy-induced immunocompromised patient with lung cancer, who was treated for pneumonia and septicaemia due to P. multocida. There was no anamnestic contact with animals, which underlines the fact that immunocompromised patients can suffer from serious systemic infections due to P. multocida – even with no known animal contact.